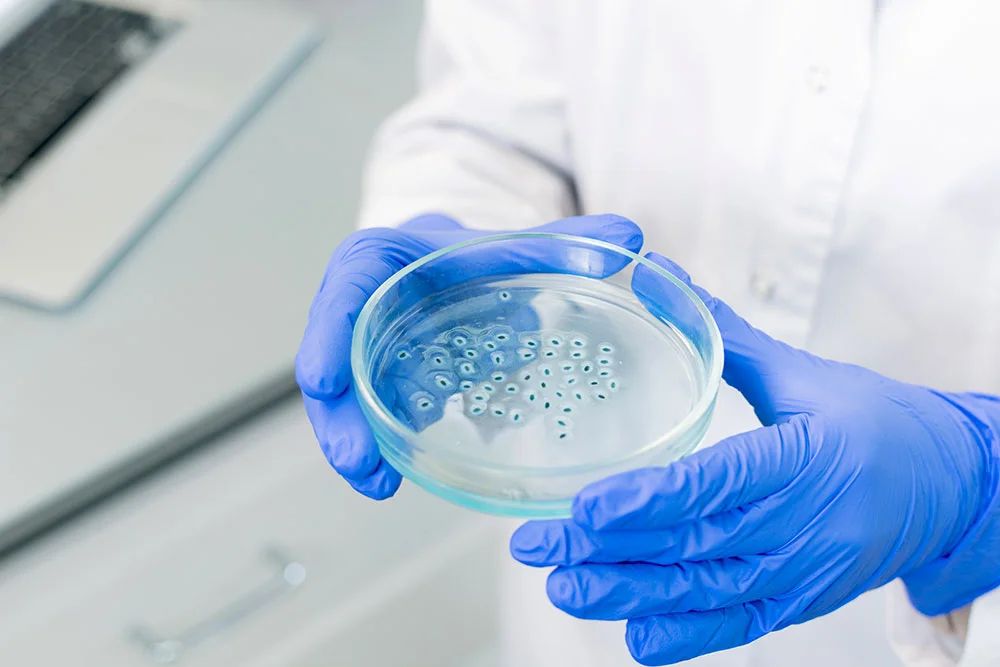

La nostra mission
La mission di Promé è quella di offrire una terapia probiotica personalizzata basata sull’utilizzo di ceppi batterici probiotici selezionati specificatamente per ripristinare/mantenere l’omeostasi del microbiota intestinale dell’uomo.
Questo avviene grazie ad una profilazione precisa e accurata del microbiota intestinale dell’individuo, basata su un protocollo di analisi metagenomica, unico nel suo genere, opportunatamente sviluppato da Promé.